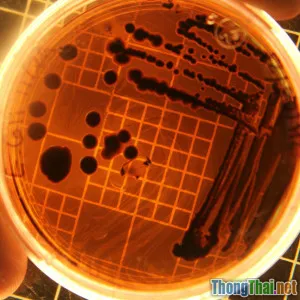
Làm thế nào để bắt đầu nghiên cứu sinh học tế bào

Công nghệ & đời sống - Khám phá những xu hướng công nghệ mới nhất và cách công nghệ ảnh hưởng tích cực đến cuộc sống hàng ngày của bạn.
Đang tải...
Xem thêm »










Bài viết phổ biến

Những phim về sự kiện lịch sử Việt Nam ít ai biết

Review dịch vụ duỗi tóc collagen ở Sài Gòn

Tạo rogue access point để kiểm tra an ninh mạng

Review top 5 robot chăm sóc sức khỏe sử dụng AI tốt nhất năm 2024

Review Top 5 ứng dụng ghi chú miễn phí tốt nhất cho iOS năm 2024

Review top 5 hàng decor tường hot nhất 2024

Làm sao vượt qua cảm giác tiêu cực bằng phương pháp thay đổi góc nhìn

Blog cá nhân và content niche ra tiền khác nhau thế nào

Bí quyết làm chủ JOIN phức hợp trong SQL hiệu quả

Đâu là những chủ đề blog dễ kiếm tiền nhất 2024
Danh mục »